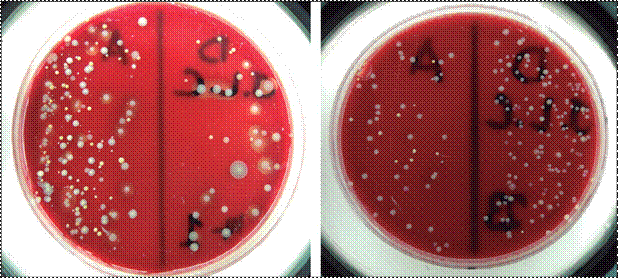

Rev.
Méd. RosaRio 86: 67-76, 2020
![]()
COMPARACIÓN DE LA EFICACIA
GERMICIDA ENTRE EL ALCOHOL EN GEL, EL JABÓN LÍQUIDO ANTIMICROBIANO Y EL JABÓN
LÍQUIDO COMÚN EN LA HIGIENE DE MANOS
denise BeRnadette
MoRejón1*, Rodolfo notaRio1,2
1Facultad
de Medicina y Ciencias de la Salud, Universidad Abierta Interamericana. 2Servicio
de Microbio- logía del Hospital Español.
Fecha de recepción:
20-12-2019 Aceptado para su publicación: 6-4-2020
Las infecciones relacionadas con la atención sanitaria afectan anualmente a millones de pacientes, pueden ser difíciles de tratar y potencialmente mortales. La higiene de manos (HM) es esencial para su prevención y es lo más eficaz para limitar la propagación de patógenos. El propósito de este trabajo fue determinar cuál de los agentes utilizados para la HM fue más eficaz como germicida. Se realizó un estudio descriptivo, prospectivo, experimental no aleatorio sobre 105 alumnos de medicina de 4to a 6to año. Las muestras se tomaron de la mano dominante de cada alumno, antes y después de la HM, mediante hisopo estéril y fueron sembradas en agar sangre (AS). Se compararon: alcohol en gel (AG) y dos jabones líquidos (antimicrobiano, JLA y común, JLC) siguiendo las recomendaciones de la OMS. Cada placa de AS fue dividida en 2 sectores: 1) previo a la HM y 2) luego de ésta. La eficacia germicida se determinó por cuantificación de las unidades formadoras de colonias (UFC) en AS. Aquellos alumnos que utilizaron JLC presentaron una reducción del 21% en las UFC; los que utilizaron JLA un 84% y aquellos que utilizaron alcohol en gel (AG) un 94%. No existió diferencia significativa entre JLA y AG (p=0,233), pero sí la hubo entre JLA y JLC (p<0,001), como así también entre AG y JLC (p<0,001). Los tres agentes disminuyeron las UFC luego de la HM. El valor de la mediana de las UFC con el AG fue menor en comparación al de los otros dos. No existió diferencia estadísticamente significativa entre AG y JLA; sin embargo, ambos agentes demostraron ser superiores en su eficacia germicida que JLC.
Palabras claves: eficacia germicida, higiene de manos, alcohol en gel, jabón líquido antimicrobiano, jabón líquido común.
COMPARISON OF
THE GERMICIDAL EFFICACY BETWEEN AN ALCOHOL-BASED HAND RUB, ANTIMICROBIAL SOAP
AND PLAIN SOAP IN HAND HYGIENE
Abstract
Health care associated infections (HCAI) affect
millions of patients
annually, can be difficult to treat and are potentially fatal. Hand hygiene (HH) is essential for the prevention of HCAI and is the most effective way to reduce
the propagation of healthcare associated pathogens. The objective of this study was to determine which agent used in HH provided the most
germicidal efficacy. A descriptive nonrandomized, prospective, experimental study
was conducted on 105 medical students between
4th and 6th year. The samples were taken
from the dominant hand of each
student, before and
after, through a sterile swab
and later cultured on a blood
agar (BA) plate.
The alcohol-based hand
rub and the
two liquid soaps (antimicrobial, AS and plain,PS) were compared, utilizing the WHO guidelines of HH. Each
BA plate was divided
into 2 sections: 1) prior
to, and 2) after HH. Germicidal efficacy
was determined by the quantification of colony-forming units (CFU)
in BA. The median values
of the CFU were compared, before and after;
by applying the nonparametric
Wilcoxon test for related samples.
Those students who used PS had a 21% reduction in CFU, those who used AS 84%, and
those who used
an alcohol-based hand
rub (AB) 94%.
There was no significant statistical difference between AS and
AB (p = 0.233), but there was a difference between AS and PS (p <0.001), as well as between AB and PS (p <0.001). In conclusion, all three agents
decreased CFU after
HH. The median value of CFU with AB was lower in comparison to the
other two agents.
There was no significant difference between AB and AS; however, both
agents proved to be superior to PS in their germicidal efficacy.
Key words: germicidal efficacy, hand hygiene, alcohol-based hand rub, antimicrobial soap, plain soap.
* Correo electrónico: denisemorejon@gmail.com
Según la OMS las infecciones relacionadas con la atención sanitaria (IRAS) afectan
anualmente a cientos de millones de pacientes en todo el mundo siendo
en ocasiones difíciles de tratar y potencialmente mortales1. Las
infecciones producen y/o complican enfermedades,
prolongan el tiempo de internación, inducen
discapacidades a largo
plazo, aumentan los
costos a los
pacientes y sus familias, incrementan el gasto
al sistema sanitario y con significativa frecuencia producen la
trágica pérdida de vidas.2
La higiene de manos (HM) constituye un buen hábito cuya finalidad es eliminar o disminuir en forma
significativa la flora
transitoria, la suciedad, y el material orgánico a través de una técnica sencilla, económica y rápida. Es un aspecto de particular importancia en la rutina de los profesionales de la salud,
debido a que los agentes potencialmente patógenos nosocomiales se transmiten principalmente a través de las manos de los trabajadores de la salud.
Así la HM es esencial
para la prevención de la IRAS y sigue siendo el método más eficaz para limitar
la propagación de agentes patógenos en el entorno
nosocomial. Sin embargo,
a pesar de la constante promoción de la HM, el
cumplimiento de la misma
entre los trabajadores sanitarios se mantiene
por debajo del 40%.3 Un estudio anterior demostró una reducción de las infecciones nosocomiales
por Klebsiella pneumoniae multirresistente al implementarse el uso de alcohol gel
(AG).4
No se dispone
en nuestro medio
de información que
vincule la eficacia
del AG, el jabón líquido
antimicrobiano (JLA)
y el jabón líquido común
(JLC) para la HM.
El propósito de este trabajo fue determinar cuál de los tres agentes utilizados en este estudio es más eficaz como germicida en la higiene de manos. Determinar la eficacia del alcohol en gel en comparación con la del JLA y el JLC en la HM, para disminuir el recuento de las UFC de la superficie de las manos.
También persigue hacer hincapié en la importancia del hábito de la HM como conducta necesaria en el ámbito de la salud como herramienta para interferir en la propagación de las enfermedades. Por lo que sabemos es el primer estudio realizado sobre la HM en estudiantes de medicina en condiciones de examinar pacientes.
Se realizó un estudio descriptivo, prospectivo, experimental no aleatorio que investigó la eficacia germicida del AG en relación a la del JLA, y el JLC en la HM. Se utilizaron: placas de agar sangre (PAS), hiso-
pos Dacrón® estériles, solución fisiológica estéril (SF) (de NaCl al 0,9%), alcohol en gel (PORTA bialcohol®), jabón líquido antimicrobiano con clorhexidina al 4% (LACLORHEX®), jabón líquido común (Palmolive®), guantes descartables no estériles, toallas descartables no estériles, tubos de ensayo estériles, estufa de cultivo a 36-37°C.
Las muestras se tomaron de las manos dominantes en 105 estudiantes de 4to, 5to y 6to año de medicina de la UAI, en el laboratorio de
Microbiología de la sede regional, antes
y después de la HM con los respectivos productos. Los alumnos se dividieron en 3
grupos: a) 35 individuos realizaron la HM con AG, b) 35
con JLA con clorhexidina al 4% y c) 35 de ellos se
lavaron con JLC. Se extrajeron de la mano
dominante mediante
hisopo estéril, previa inmersión del mismo en 10mL de SF estéril
contenida en un tubo de ensayo estéril.
Con el hisopo
humedecido se procedió a la recolección de la muestra
sobre la superficie palmar, superficie
palmar de sus dedos índice
y pulgar y el espacio interdigital entre estos. Cada una de las placas de
agar sangre (PAS) utilizadas fue dividida por una línea en 2 sectores iguales: previo a su
lavado (denominado “Antes”) y en el otro sector
(denominado “Después”) donde se sembró la muestra
obtenida de la misma mano del estudiante luego de la higiene de esta con
el agente seleccionado. Una vez sembrada,
cada PAS fue incubada
a 37°C durante
36-48 horas y posteriormente se realizó la cuantificación de las UFC de cada
compartimento, “Antes” y “Después”. Como herramienta de ayuda para el recuento
se utilizó la aplicación ColonyCount® desarrollada para tal tarea; utilizándose esta
como instrumento de control.
La metodología para la HM con los diferentes productos estuvo estandarizada de acuerdo a las recomendaciones planteadas en las guías de la OMS (2009), para el lavado de manos.1 Todos los participantes del estudio recibieron una breve instrucción por parte del experimentador de cómo realizar el procedimiento. Las manos y la ropa del participante del estudio se mantuvieron en todo momento lejos de la superficie de la pileta y cualquier otro objeto que pudiera contaminar- las y todo artículo de joyería fueron retirados previos al inicio de la HM. Los participantes recibieron la misma cantidad de producto, entre 3-5mL (una aplicación), el cual fue dispensado por parte del experimentador. Cada sujeto se lavó las manos por no más de 60 segundos en el caso de los jabones líquidos y no más de 30 segundos en el caso del AG, siendo en todos los casos cronometrado por el experimentador.
Criterios de inclusión:
Alumnos de 4to, 5to y 6to año de medicina que estaban concurriendo a clases en forma regular y que frecuentaban ambientes sanitarios con pacientes hospitalizados.
Alumnos que colaboraron de forma espontánea. Criterios de exclusión:
Alumnos que realicen un procedimiento de HM
que no se rija por las pautas
estandarizadas de la OMS1 (2009).
Alumnos que se higienizaron las manos previa- mente a la toma de muestra.
Alumnos de otras carreras.
Alumnos de medicina de 1ro, 2do y 3er año que no concurren a ambientes sanitarios.
Consentimiento Informado: Los voluntarios firmaron un consentimiento informado avalando la técnica utilizada para la HM. Dicho documento expresa además los objetivos de la investigación y asegura que los datos recogidos tendrán carácter de confidencialidad.
Consideraciones Éticas: Toda la información personal obtenida para este estudio fue estrictamente confidencial, conforme a la ley de protección de los datos personales N°25.326. No se incluyeron los nombres de los participantes del estudio, ni sus iniciales.
Análisis Estadístico: Se utilizaron gráficos de dispersión, gráficos de barras y de cajas (conocidos también como boxplot). Para la comparación de los valores medios de las UFC, antes y después de la HM, se aplicó el test no paramétrico de Wilcoxon para mues- tras relacionadas. Se compararon los métodos propuestos para la HM con sus correspondientes productos a través del test no paramétrico de Kruskal-Wallis y se utilizaron comparaciones múltiples para verificar cuál de ellos era el más eficaz en disminuir las UFC. Se utilizó el software estadístico SPSS y se consideraron estadísticamente significativas las pruebas de hipótesis con valores de probabilidad asociada (p) inferiores al 5% (p<0.05).
En la Figura 1 se muestra la distribución de los datos experimentales. Los círculos representan los va- lores individuales de las UFC hallados para cada estudiante y las líneas unen los valores promedios de las UFC antes y después de haber aplicado cada uno de los agentes para la HM (figuras 1a, 1b y 1c). En todos los grupos se demostró que la frecuencia (recuento) de las UFC disminuyó luego de aplicar cualquiera de los agentes para la HM.
En la Figura 2 se puede observar el porcentaje de disminución en el recuento de las UFC luego de la HM, de acuerdo a cada agente utilizado. Aquellos estudiantes que utilizaron el JLC para la HM presentaron una reducción del 21% en el recuento de las UFC; mientras


Figura 1. Distribución de los estudiantes según el momento de la medición y los valores de UFC para los distintos agentes empleados.
que los que utilizaron JLA tuvieron una disminución del 84% en las UFC y los que se higienizaron las manos con AG presentaron una reducción del 94% de las UFC. La Figura 2 muestra que el AG fue el más eficaz de los productos comparados para reducir las UFC luego de una HM.
Para verificar lo observado, se aplica el test esta- dístico de Wilcoxon para muestras relacionadas, que permite comparar si el valor de la mediana de las UFC antes de aplicar un agente determinado para la HM es el mismo que después de este. En la Tabla 1 se exponen los resultados de los tests para cada uno de los agentes. Se observó que con el uso del AG, todos los recuentos presentaron diferencias negativas, es decir que todos tuvieron menor recuento de las UFC después de la HM que antes del mismo. Por su parte, de los 35 estudiantes que usaron JLA hubo 2 de ellos que presentaron diferencias positivas, es decir que en 2 estudiantes el número de UFC después de la HM fue mayor que antes de esta. Este mismo hallazgo se observó en 10 de los 35 estudiantes que recibieron JLC. Observando las probabilidades asociadas correspondientes al test de Wilcoxon para muestras relacionadas, se observó que en todos los casos existe diferencia significativa entre los valores de las medianas de las UFC antes y después

Figura 2: Porcentaje de reducción de las UFC para cada uno de los agentes luego de la HM.
Agente Valor de Antes la
mediana Después Difere Positivas ncias* Negativas Probabilidad
asociada Alcohol en
gel 98 3 0 35 <0,001 Jabón líquido 132 7 2 33 <0,001 Jabón líquido común 123 79 10 25 0,015
Tabla 1. Resultados del test de
Wilcoxon para cada agente.
antimicrobiano
*Cantidad de UFC después de
recibir el agente menos la cantidad de UFC antes de recibir el agente.
de la HM, dado que las probabilidades asociadas son menores al 5%.
Si bien los tres agentes disminuyeron el recuento de las UFC, se quiso evaluar de forma estadística cuál fue el más eficaz de ellos. En la Figura 3, se observa que el valor de la mediana de las UFC con el de AG fue menor en comparación a los otros dos agentes; se destaca, además, una mayor variabilidad con el del JLC.
Luego del análisis descriptivo de los datos, se pro- cedió a comparar los tres agentes para la HM a través del test estadístico Kruskal-Wallis, el cual se usa para probar la hipótesis nula de la igualdad de eficacias de los tres agentes, contra la hipótesis alternativa de que al menos uno de ellos difiere en su eficacia. Al aplicar dicho test se confirmó estadísticamente que al menos uno de los agentes difirió (p<0,0001). Dado que se rechaza la hipó- tesis nula de que los tres agentes son igualmente eficaces, es de interés comparar los agentes entre sí. Es por ello que se realizaron comparaciones múltiples.
En la Tabla 2 se observa que no existieron diferencias estadísticamente significativas entre el JLA y el AG (p=0,233); pero sí hubieron diferencias significativas entre el JLA y el del JLC (p<0,001) y entre el AG y el JLC (p<0,001).
Aunque en la Figura 3 se pudo observar que el AG fue el más eficaz de los agentes para reducir las UFC, en base a los resultados obtenidos se demuestra que no existen diferencias significativas entre el AG y el JLA en la HM de los estudiantes analizados; y que ambos agentes a su vez son superiores al JLC.
Tabla 2. Resultados de las comparaciones entre los agentes.
|
Comparación |
Diferencia de rangos |
Probabilidad asociada |
|
Jabón líquido
antimicrobiano vs. alcohol en gel |
14,10 |
0,233 |
Jabón líquido común vs. alcohol en gel
Jabón
líquido común vs. jabón líquido antimicrobiano

52,93 <0,001
38,83 <0,001
![]()

Figura 3. Distribución de los estudiantes según el agente utilizado y los valores de UFC.
En las figuras 4, 5 y 6 se pueden observar algunos ejemplos que demuestran la eficacia germicida de los diferentes agentes utilizados para la HM, en los estudiantes de medicina. Se comparan ambos lados de cada PAS mediante el recuento de las UFC: antes de la HM (izquierda) y después de esta (derecha).
En todos los grupos el recuento
de las UFC disminuyó luego de aplicar
cualquiera de los tres agentes.
Se reafirma de este modo la importancia de la HM en cualquier ámbito, en particular entre los trabajadores sanitarios para limitar
la propagación de agentes patógenos y lograr así la prevención de las IRAS,
como lo expresó
Bischoff et al., en su trabajo
en el año 2000.3
Se pudo demostrar que el JLA resultó 3 veces más eficaz que el JLC en la reducción de las UFC luego de la HM y que el AG supera en casi 4 veces la eficacia

Figura 4. Eficacia del alcohol en gel en la reducción de las UFC antes (mitad izquierda de la placa de agar sangre y después (mitad derecha) de la HM en dos de los estudiantes que emplearon alcohol gel.

Figura 5. Eficacia del jabón líquido antimicrobiano en la reducción de las UFC antes (mitad izquierda de la placa de agar sangre) y después (mitad derecha) de la HM en dos de los estudiantes que emplearon jabón líquido antimicrobiano.
germicida del JLC, lo que concuerda con otros autores5-8 y que la eficacia de los agentes
antisépticos contenidos en el JLA y el AG es significativamente mayor en la reducción de la flora de la piel que la HM con
agua y jabón común. Es de destacar que este último,
aunque no posea propiedades antibacterianas o antisépticas re- dujo el recuento
de las UFC en un 21%, coincidiendo con Boyce y Pittet, quienes
demostraron que la HM con agua y jabón puede
remover las capas
más superficiales de
bacterias adheridas a la piel.
El AG suele ser más eco-
nómico, requiere menos tiempo, es menos propenso a causar dermatitis de contacto y favorece la adherencia por parte del personal de salud.6,7
En 10 de los 35 estudiantes que utilizaron JLC, el número de las UFC después de la HM fue mayor que antes de esta. Este mismo hallazgo se observó en sólo 2 de los 35 estudiantes que recibieron JLA. Este fenómeno paradojal no se halló con el uso del AG, en donde
Figura 6. Eficacia germicida del jabón líquido común para la reducción de las UFC antes (mitad izquierda de la placa de agar sangre) y después (mitad derecha) de la HM en dos de los estudiantes. Nótese que en la placa del estudiante a la derecha (placa 23) se obtuvo mayor número de UFC después de la HM, un resultado paradojal.
se evidenció menor recuento de las UFC en todas las muestras después de la HM.
Un estudio
realizado por Ehrenkranz y Alfonso demostró
que al lavarse con agua y jabón
común no se consiguió eliminar los microorganismos
de las manos del personal de salud y que paradójicamente lavarse las manos con jabón común podía aumentar
el número de bacterias en la superficie de la piel.9
Los hallazgos paradójicos, de aumento en el re- cuento de las UFC encontrados luego de la HM con los jabones líquidos (tanto antimicrobiano
como común), podrían deberse
en parte a 1) la contaminación de la
toalla descartable (no estéril)
utilizada para el secado de las manos, 2) el arrastre de
microorganismos desde el antebrazo
y la muñeca hacia la mano durante
el seca- do, 3) a que
la HM logra eliminar tan
solo las bacterias más superficiales (flora transitoria, recientemente adquiridas y potencialmente más peligrosas) permaneciendo
la flora
residente de cada
individuo, 4) a que la mano
permanezca todavía
húmeda al momento
de la toma de la
muestra, lo cual
implica una mayor
adherencia de los microorganismos al hisopo. En
relación a esto ha sido motivo de estudio la transmisión de organismos a través
de telas artificialmente contaminadas (tela donante) a telas limpias (tela
receptora) vía contacto
de las manos.10
Los resultados indicaron que el número de microorganismos transmitidos era mayor desde la tela donante a la tela receptora cuando las manos estaban mojadas en el momento del contacto.
Recientemente se ha publicado en la guía Hand Hygiene in Healthcare Settings
por el CDC, que los antisépticos para manos a base de alcohol son los productos más eficaces para reducir el número de gérmenes en las manos de los profesionales de la
salud. Resultados similares fueron
referidos por la Sociedad Nacional
de Control de Infecciones de Inglaterra en 2014.7-11
Cabe agregar
que la fricción de manos con una sustancia
a base de alcohol fue recomendada por
sobre el lavado de manos
con jabón común
o jabón antiséptico al revelar mejor tolerancia de la piel.12
En cambio un estudio
realizado por Delgado
y Zabalza (2005) concluyó que en el grupo que
utilizó AG tras
la HM había una reducción en el recuento
bacteriológico más elevada
(reducción del 83%),
en relación con el grupo
que realizó la HM con un jabón líquido
antiséptico (reducción del 58%)13. En el presente trabajo como ya se mencionó, los estudiantes que utiliza-
ron AG presentaron una reducción
del 94% de las UFC en relación a antes de la HM, y los que se higienizaron
las manos con JLA tuvieron una
disminución del 84% en las UFC. Ambos trabajos
demostraron una mayor reducción en las UFC al utilizar
un agente a base de alcohol.
En el presente trabajo se observó que, si bien el AG logró una mayor reducción en el contenido microbiano de la piel que el JLA no existió diferencia esta- dísticamente
significativa. En cuatro de cinco ensayos controlados aleatorios en entornos
clínicos se observó que las preparaciones a base de alcohol eran más eficaces como agente de HM que los jabones
antisépticos, mientras un quinto estudio no encontró
ninguna diferencia estadística entre el uso de preparaciones a base de alcohol y jabón
antiséptico.5
Adicional a los objetivos planteados en esta investigación se observó que las diferencias en la reducción de las UFC obtenidas entre distintos trabajos podría deber- se
entre otras, a cuestiones relacionadas con la técnica
empleada para la HM (el volumen del
producto higiénico aplicado, el tiempo de contacto del agente con la piel, el método
usado para recoger
los microorganismos de la piel, etc.), el tipo de agente utilizado así como su concentración. En relación
al volumen del agente utilizado, Mackintosh y Hoffman aportaron que aplicar pequeños volúmenes (0,2-0,5mL) de alcohol en las manos
no es más efectivo que lavar las manos con jabón común y
agua.14 Por último, en un estudio realizado por Larson y col., se documentó que 1ml de alcohol en gel es considerablemente menos efectivo
que 3 ml del mismo.15
Además, el método para expresar la eficacia del producto antiséptico puede
diferir, es decir puede ser expresado en porcentaje de reducción de los microorganismos o como registro
logarítmico de la reducción de estos, sobre la piel.
Por otra parte, no se ha establecido
de modo contundente el grado
necesario de reducción
de los microorganismos en las manos para disminuir al mínimo la transmisión de patógeno en ámbitos sanita- rios.16-17 Se desconoce si el recuento microbiano en las manos se debe reducir
a 1 log10 (reducción del 90%),
2 log10 (el 99%), 3 log10 (99.9%) o 4 log10 (99.99%).18-19
El nivel de contaminación previa de las manos de los in- dividuos participantes de este y otros estudios representa una variable de difícil control y una de las limitaciones a superar en futuras investigaciones.
Numerosos médicos, enfermeros y otras personas de las instituciones asistenciales que adhieren a la HM no realizan ésta con el procedimiento recomendado en la OMS
Este tipo de estudio en un ámbito controlado no refleja la habitual conducta para la HM en el personal sanitario. Los voluntarios participantes del mismo fue- ron estudiantes avanzados de la carrera de Medicina con participación periódica de prácticas en centros de salud. No obstante, la microbiota de sus manos puede no ser representativa de la microbiota del personal que trabaja en las instalaciones sanitarias. Sería interesante en un fu- turo realizar otros estudios en el personal sanitario.
Actualmente la promoción de la HM debe ser considerada como una prioridad a nivel mundial, tanto por parte de los futuros médicos como entre todos los profesionales de la salud. Todos los esfuerzos orientados a cumplir con este importante desafío tendrán grandes implicancias en su objetivo final como es la prevención de enfermedades, la mejora en la seguridad y calidad de vida de los pacientes y la disminución de la morbimoratalidad relacionado con las IRAS.
En este trabajo se pudo concluir que los tres agentes disminuyeron el recuento de las UFC luego de la HM. Si bien hubo una mayor disminución del recuento de las UFC con el AG respecto del JLA, no hubo diferencia estadísticamente significativa entre ellos. Sin embargo, ambos agentes demostraron ser significativa- mente superiores al JLC. El JLC también disminuyó el número de UFC por lo que se recomienda efectuar la HM previa al uso de AG.
En base a la bibliografía consultada, la evidencia actual orienta cada vez más hacia el uso de una fricción de manos con un agente antiséptico a base de alcohol en el ámbito sanitario por ser un método económico, más rápido, fácil de emplear, que produce menor irritación y sequedad de la piel y ayuda a cumplir con la adherencia por parte del personal de salud. Salvo en aquellos casos en que las manos estén visiblemente contaminadas por suciedad, en cuyos casos la HM con agua y jabón (anti- microbiano o no) tiene su principal indicación.
Bibliografia
1. OMS. Guía de aplicación de la estrategia multimodal de la OMS para la mejora de la higiene de las manos. Geneva: WHO Press, Geneva, 2009.
2. Schlossberg D. (Ed.). Clinical infectious disease. Cam- bridge University Press,2015.
3. Bischoff W E, Reynolds TM, Sessler CN y col. Handwas- hing compliance by health care workers: the impact of intro- ducing an accessible, alcohol-based hand antiseptic. Arch. Intern. Med.160:017-102, 2000.
4. Bermejo J, Wertz A, Bencomo P y col. Efecto del uso de al- cohol en gel sobre las infecciones nosocomiales por Klebsiella pneumoniae multirresistente. Medicina (Buenos Aires), 63:715-720, 2003
5. Pratt RJ, Pellowe CM, Wilson JA y col. epic2: National evidence-based guidelines for preventing healthcare-associa- ted infections in NHS hospitals in England. J. Hosp. Infect, 65:S1-S59, 2007.
6. Boyce JM, Pittet, D. Guideline for hand hygiene in health- care settings: recommendations of the Healthcare Infection Control Practices Advisory Committee and the HICPAC/ SHEA/APIC/IDSA Hand Hygiene Task Force. Am J Infec Control 30: S1-S46, 2002.
7. Loveday HP, Wilson J, Pratt RJ y col. epic3: national evi- dence-based guidelines for preventing healthcare-associated infections in NHS hospitals in England. J Hosp, Infect 86 S1:S1-70, 2014.
8. Widmer A F. Replace hand washing with use of a waterless alcohol hand rub? Clinical Infectious Diseases, 31:136- 143, 2000.
9. Ehrenkranz NJ, Alfonso BC. Failure of bland soap hand- wash to prevent hand transfer of patient bacteria to urethral catheters. Infect Control & Hosp Epidemiol, 12: 654- 662, 1991.
10. Marples RR, Towers AG. A laboratory model for the in- vestigation of contact transfer of microorganisms. J Hyg (Lond), 82:237-248,1979.
11. CDC. Hand Hygiene in Healthcare Settings . Recupera- do el 31/5/2016 de http://www.cdc.gov/handhygiene/ index.html 2016.
12. Tavolacci MP, Pitrou I, Merle V. y col. Surgical hand rub- bing compared with surgical hand scrubbing: comparison of efficacy and costs. Journal of Hospital Infection, 63:55-59, 2006.
13. Delgado RMR, Zabalza OU. Eficacia del lavado de manos con solución de base alcohólica versus el lavado de manos estándar con jabón antiséptico: ensayo clínico controlado y aleatorizado. Enfermería Global, 4:1, 2005.
14. Mackintosh CA, Hoffman PN. An extended model for transfer of micro-organisms via the hands: differences bet- ween organisms and the effect of alcohol disinfection. J. hyg. (Lond) 92: 345-355,1984.
15. Larson EL, Eke PI, Wilder MP, Laughon BE. Quantity of soap as a variable in handwashing. Infect Control 8:371- 375, 1987.
16. Rotter ML. Hand washing and hand disinfection. Hosp. Epidemiol Infect. Control 2:1339-1355,1999.
17. Larson EL, Morton HE. Alcohols. In Block SS.Ed. Disin- fection, sterilization, and preservation.4th ed. Lea & Febi- ger. 191-203. Philadelphia, 1991.
18. Sattar SA, Abebe M, Bueti AJ y col. Activity of an alcohol- based hand gel against human adeno-, rhino-, and rotavi- ruses using the fingerpad method. Infect. Control Hosp. Epidemiol 21:516-519, 2000.
19. Steinmann J. Some principles of virucidal testing. J Hosp Infect 48:S15-S17, 2001.